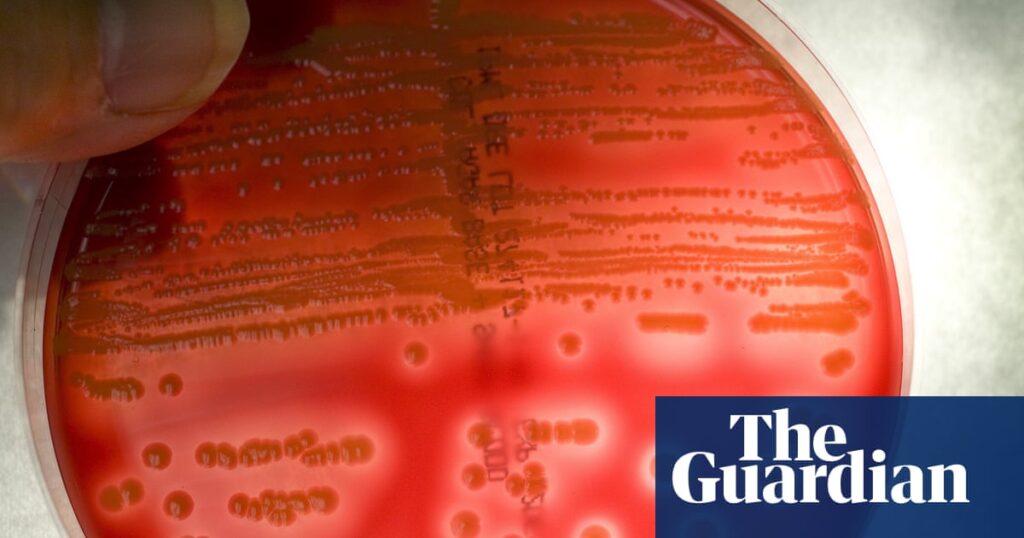
EPA urged to ban spraying of antibiotics on US food crops amid resistance fears | Pesticides

England’s water industry issued £10.5bn in ‘green bonds’ despite pollution record | Water industry
Research indicates that water companies in the UK have issued approximately 20% of the nation’s green bonds since 2017, despite facing ongoing criticism regarding sewage pollution during the same period. Analysis conducted by Unearthed, a project affiliated with Greenpeace UK, reveals that privately owned water companies in England have raised £10.5 billion through these bonds, […]